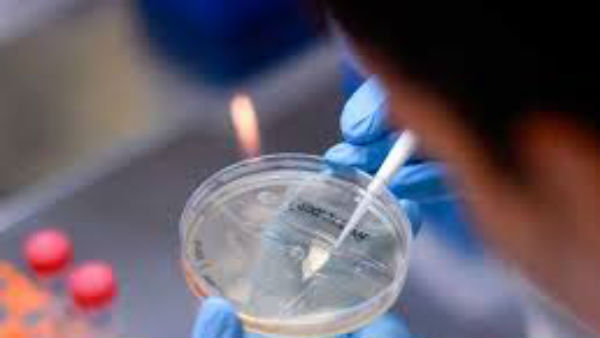
ఇండియా నుండి మలేసియా వెళ్ళిన వ్యక్తిలో గుర్తింపు .. ఫిలిప్పీన్స్ ప్రజల్లో కూడా

కరోనా కొత్త జన్యువు .. యమా డేంజర్ ... పదిరెట్లు వేగంతో, మరింత తీవ్రంగా ప్రభావం
కరోనావైరస్ మరింత డేంజర్ గా రూపాంతరం చెందుతోంది. తాజాగా కరోనావైరస్ కు సంబంధించిన కొత్త జన్యువును గుర్తించారు మలేషియా శాస్త్రవేత్తలు.ఈ కొత్తరకం కరోనా వైరస్ జన్యువును D614G అని పేర్కొన్నారు. ఇది అత్యంత ప్రమాదకరమైన జన్యు పరిణామమని, ఇది ప్రస్తుతం ఉన్న కరోనా వైరస్ కు పదిరెట్లు అధికంగా వ్యాప్తిని కలిగి ఉందని,తీవ్రతను కూడా కలిగి ఉందని పేర్కొన్నారు.
Recommended Video

కరోనా వైరస్ కొత్త జన్యువు ... ఉత్పరివర్తనంతో డేంజర్ బెల్స్
గతంలో పలుదేశాలలో ఈ జన్యువులను ఇప్పటికే గుర్తించారని, తాజాగా ఫిలిప్పీన్స్ నుండి తిరిగి వచ్చే వ్యక్తులతో కూడిన మరొక క్లస్టర్ లో ఈ మ్యూటేషన్ జాతి కనుగొనబడింది అని వారు పేర్కొన్నారు. కరోనా వైరస్ జన్యు ఉత్పరివర్తనం యూరప్ మరియు ఐరోపా దేశాలలో చాలా ప్రమాదకరంగా మారింది. మలేషియాలో కూడా ప్రస్తుతం కరోనా వైరస్ కొత్త జన్యువు కనుగొనబడిన కారణంగా ప్రజలు అప్రమత్తంగా ఉండాలని ,ఎక్కువ జాగ్రత్తలు తీసుకోవాలని చెబుతున్నారు. ప్రజల సహకారం ఉంటే కరోనా వైరస్ కొత్త జన్యువు నుండి వేగంగా జరిగే వ్యాప్తిని కొంతమేరకు తగ్గించవచ్చని చెప్తున్నారు.
ఇండియా నుండి మలేసియా వెళ్ళిన వ్యక్తిలో గుర్తింపు .. ఫిలిప్పీన్స్ ప్రజల్లో కూడా
ఇది భారతదేశం నుండి తిరిగి వచ్చిన ఒక రెస్టారెంట్ యజమానిలో కనిపించింది . ఇండియా నుండి తిరిగి వచ్చాక అతనికి 14 రోజుల క్వారంటైన్ విధించారు . అయితే ఆ వ్యక్తి నిబంధనలు ఉల్లంఘించి బయట తిరగటంతో ఆ వ్యక్తికి ఐదు నెలల జైలు శిక్ష మరియు జరిమానా విధించబడింది. ఈ క్రమంలో అతనికి పరీక్షలు జరుపగా అతనిలో కరోనా కొత్త జన్యువు కనిపించింది . ఫిలిప్పీన్స్ నుండి వచ్చే వారిలోనూ ఈ జన్యువు కనిపించింది .

కొత్త జన్యు ఉత్పరివర్తనంతో వ్యాక్సిన్ సామర్ధ్యంపై అనుమానాలు
ఈ నేపథ్యంలో ప్రస్తుతం కరోనా వైరస్ కు తయారు చేస్తున్న వ్యాక్సిన్ ల సామర్థ్యంపై అనుమానాలు వ్యక్తమవుతున్నాయి. కానీ ప్రస్తుతం ప్రపంచమంతా కరోనా వైరస్ నిర్మూలనకోసం అభివృద్ధి చేస్తున్న వ్యాక్సిన్ల సామర్థ్యంపై మ్యుటేషన్ పెద్ద ప్రభావాన్ని చూపే అవకాశం లేదు అని సెల్ ప్రెస్ పత్రికలో ప్రచురించబడిన ఒక పరిశోధనాత్మక కథనం పేర్కొంది.
అయితే టాప్ ఇమ్యునాలజిస్ట్ లు మాత్రం కరోనా వైరస్ కొత్త జన్యువు వేగంగా వ్యాప్తి చెందుతుందని, తీవ్రంగా ప్రభావం చూపిస్తోందని అనుమానాలు వ్యక్తం చేస్తున్నారు.

మలేషియన్లు అప్రమత్తంగా ఉండాలని సూచన
ఇప్పటికే వ్యాక్సిన్ పై కొనసాగుతున్న ప్రయోగాలు, అధ్యయనాలు మ్యుటేషన్కు వ్యతిరేకంగా అసంపూర్తిగా ఉన్నవని లేదా పనికిరానివని మలేషియా హెల్త్ జనరల్ డైరెక్టర్ నూర్ హిషాం అబ్దుల్లా చెప్పారు. మలేషియన్ ప్రజలు ఈ విషయాన్ని అర్థం చేసుకొని జాగ్రత్తలు తీసుకోవాలని ఆయన పేర్కొన్నారు.
ప్రపంచంలో కరోనా వైరస్ విపరీతంగా పెరుగుతున్న నేపథ్యంలోనూ మలేషియా కరోనా కట్టడిని సమర్థవంతంగా నిర్వహిస్తుంది. అయినప్పటికీ దేశంలో కేసులు పెరుగుతున్నాయి. ఇదే సమయంలో కరోనా ఉత్పరివర్తన చెంది కొత్త జన్యువుగా మారడం కూడా మలేషియన్ లలో కనిపిస్తుంది.












Click it and Unblock the Notifications